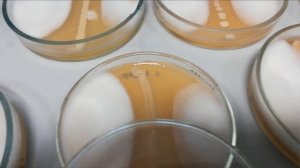
Как сенная палочка борется с кладоспориозом. Приглашение на семинар 13-03-2019.

2:46
2:46
2024-11-13 15:48

 1:00:29
1:00:29

 1:00:29
1:00:29
2024-01-01 03:17
![[Хроники StarCraft] ПЕРВЫЙ КОНТАКТ Конфедерации терранов с ЗЕРГАМИ](https://pic.rutubelist.ru/video/53/ef/53efaece433ce318770b2f12514010c2.jpg?width=300)
 16:04
16:04
![[Хроники StarCraft] ПЕРВЫЙ КОНТАКТ Конфедерации терранов с ЗЕРГАМИ](https://pic.rutubelist.ru/video/53/ef/53efaece433ce318770b2f12514010c2.jpg?width=300)
 16:04
16:04
2023-12-06 16:16

 14:24
14:24

 14:24
14:24
2023-11-25 04:25

 23:08
23:08

 23:08
23:08
2024-12-16 15:00

 45:54
45:54

 45:54
45:54
2024-10-14 23:11
![I'll See You There Tomorrow — Tomorrow X Together | K-POP Random [MICHIN dance studio]](https://pic.rutubelist.ru/video/62/57/62576f4e11bab04000a8f24404d2972c.jpg?width=300)
 1:48
1:48
![I'll See You There Tomorrow — Tomorrow X Together | K-POP Random [MICHIN dance studio]](https://pic.rutubelist.ru/video/62/57/62576f4e11bab04000a8f24404d2972c.jpg?width=300)
 1:48
1:48
2024-05-05 12:00

 10:07
10:07

 10:07
10:07
2024-09-02 05:24

 0:48
0:48

 0:48
0:48
2025-05-08 04:44

 3:55
3:55

 3:55
3:55
2023-11-17 07:51

 1:44
1:44

 1:44
1:44
2024-01-01 05:25

 2:03
2:03

 2:03
2:03
2023-08-11 17:13

 2:14
2:14

 2:14
2:14
2023-08-23 16:03

 1:45
1:45

 1:45
1:45
2023-09-02 16:12

 9:12
9:12
9:12
9:12
2023-08-31 13:46

 2:34
2:34

 2:34
2:34
2023-08-07 22:17

 11:40
11:40

 11:40
11:40
2023-08-22 14:30

 2:01
2:01
![Гайрат Усмонов - Унутаман (Премьера клипа 2025)]() 5:17
5:17
![Абдуллах Борлаков, Мекка Борлакова - Звездная ночь (Премьера клипа 2025)]() 4:25
4:25
![Бахром Мирзо - Дустим (Премьера клипа 2025)]() 4:45
4:45
![Бобур Ахмад - Куролмаслар (Премьера клипа 2025)]() 3:33
3:33
![Иброхим Уткиров - Коракуз (Премьера клипа 2025)]() 4:28
4:28
![Tural Everest, Baarni - Ушедший покой (Премьера клипа 2025)]() 3:01
3:01
![Руслан Шанов - Особенная (Премьера клипа 2025)]() 2:16
2:16
![Cvetocek7 - Запретила (Премьера клипа 2025)]() 2:49
2:49
![BITTUEV - Не плачь (Премьера клипа 2025)]() 2:18
2:18
![Бриджит - Ласковый май (Премьера клипа 2025)]() 3:20
3:20
![Вусал Мирзаев - Слов не надо (Премьера клипа 2025)]() 2:19
2:19
![Искандар Шокалонов - Дустларим (Премьера 2025)]() 4:00
4:00
![Надежда Мельянцева - Котёнок, не плачь (Премьера клипа 2025)]() 3:02
3:02
![Кравц - Пусть музыка играет (Премьера клипа 2025)]() 3:01
3:01
![EDGAR - Мой брат (Премьера клипа 2025)]() 3:33
3:33
![Марина Хлебникова, Russell Ray - Солнышко (Премьера клипа 2025)]() 4:42
4:42
![KAYA - Девочки, отмена (Премьера клипа 2025)]() 3:53
3:53
![Жамхур Хайруллаев - Битта дона (Премьера клипа 2025)]() 2:49
2:49
![Мохито, DJ DimixeR - Перед рассветом (Премьера клипа 2025)]() 2:29
2:29
![NIKA DUBIK, Winter Spirit - Искры (Премьера клипа 2025)]() 4:27
4:27
![Французский любовник | French Lover (2025)]() 2:02:20
2:02:20
![Кровавый четверг | Thursday (1998) (Гоблин)]() 1:27:51
1:27:51
![Баллада о маленьком игроке | Ballad of a Small Player (2025)]() 1:42:60
1:42:60
![Бешеные псы | Reservoir Dogs (1991) (Гоблин)]() 1:39:10
1:39:10
![Стив | Steve (2025)]() 1:33:34
1:33:34
![Плохой Cанта 2 | Bad Santa 2 (2016) (Гоблин)]() 1:28:32
1:28:32
![Порочный круг | Vicious (2025)]() 1:42:30
1:42:30
![Грязь | Filth (2013) (Гоблин)]() 1:37:25
1:37:25
![От заката до рассвета | From Dusk Till Dawn (1995) (Гоблин)]() 1:47:54
1:47:54
![Фантастическая четвёрка: Первые шаги | The Fantastic Four: First Steps (2025)]() 1:54:40
1:54:40
![Большой Лебовски | The Big Lebowski (1998) (Гоблин)]() 1:56:59
1:56:59
![Терминатор 2: Судный день | Terminator 2: Judgment Day (1991) (Гоблин)]() 2:36:13
2:36:13
![Трон: Арес | Tron: Ares (2025)]() 1:52:27
1:52:27
![Отчаянный | Desperado (1995) (Гоблин)]() 1:40:18
1:40:18
![Карты, деньги, два ствола | Lock, Stock and Two Smoking Barrels (1998) (Гоблин)]() 1:47:27
1:47:27
![Чумовая пятница 2 | Freakier Friday (2025)]() 1:50:38
1:50:38
![Орудия | Weapons (2025)]() 2:08:34
2:08:34
![Богомол | Samagwi (2025)]() 1:53:29
1:53:29
![Гедда | Hedda (2025)]() 1:48:23
1:48:23
![Шматрица | The Matrix (1999) (Гоблин)]() 2:17:10
2:17:10
![Мотофайтеры]() 13:10
13:10
![Новое ПРОСТОКВАШИНО]() 6:30
6:30
![Минифорс. Сила динозавров]() 12:51
12:51
![Приключения Пети и Волка]() 11:00
11:00
![Панда и петушок Лука]() 12:12
12:12
![Команда Дино. Исследователи Сезон 1]() 13:10
13:10
![Простоквашино]() 6:48
6:48
![Пип и Альба Сезон 1]() 11:02
11:02
![Команда Дино. Исследователи Сезон 2]() 13:26
13:26
![Супер Дино]() 12:41
12:41
![Кадеты Баданаму Сезон 1]() 11:50
11:50
![Пиратская школа]() 11:06
11:06
![Шахерезада. Нерассказанные истории Сезон 1]() 23:53
23:53
![МегаМен: Полный заряд Сезон 1]() 10:42
10:42
![Забавные медвежата]() 13:00
13:00
![Сборники «Зебра в клеточку»]() 45:30
45:30
![Лудлвилль]() 7:09
7:09
![Сборники «Простоквашино»]() 1:05:35
1:05:35
![Последний книжный магазин]() 11:20
11:20
![Синдбад и семь галактик Сезон 1]() 10:23
10:23

 2:01
2:01Скачать видео
| 426x240 | ||
| 640x360 | ||
| 854x480 |
 5:17
5:17
2025-11-06 13:07
 4:25
4:25
2025-11-07 13:49
 4:45
4:45
2025-11-04 18:26
 3:33
3:33
2025-11-02 10:17
 4:28
4:28
2025-11-03 15:38
 3:01
3:01
2025-10-31 13:49
 2:16
2:16
2025-10-31 12:47
 2:49
2:49
2025-11-04 17:50
 2:18
2:18
2025-10-31 15:53
 3:20
3:20
2025-11-07 13:34
 2:19
2:19
2025-11-07 14:25
 4:00
4:00
2025-11-02 10:12
 3:02
3:02
2025-10-31 12:43
 3:01
3:01
2025-11-07 14:41
 3:33
3:33
2025-11-07 13:31
 4:42
4:42
2025-11-06 13:16
 3:53
3:53
2025-11-06 12:59
 2:49
2:49
2025-11-06 13:20
 2:29
2:29
2025-11-07 13:53
 4:27
4:27
2025-10-31 16:00
0/0
 2:02:20
2:02:20
2025-10-01 12:06
 1:27:51
1:27:51
2025-09-23 22:52
 1:42:60
1:42:60
2025-10-31 10:53
 1:39:10
1:39:10
2025-09-23 22:53
 1:33:34
1:33:34
2025-10-08 12:27
 1:28:32
1:28:32
2025-10-07 09:27
 1:42:30
1:42:30
2025-10-14 20:27
 1:37:25
1:37:25
2025-09-23 22:52
 1:47:54
1:47:54
2025-09-23 22:53
 1:54:40
1:54:40
2025-09-24 11:35
 1:56:59
1:56:59
2025-09-23 22:53
 2:36:13
2:36:13
2025-10-07 09:27
 1:52:27
1:52:27
2025-11-06 18:12
 1:40:18
1:40:18
2025-09-23 22:53
 1:47:27
1:47:27
2025-09-23 22:52
 1:50:38
1:50:38
2025-10-16 16:08
 2:08:34
2:08:34
2025-09-24 22:05
 1:53:29
1:53:29
2025-10-01 12:06
 1:48:23
1:48:23
2025-11-05 19:47
 2:17:10
2:17:10
2025-09-23 22:53
0/0
 13:10
13:10
2024-11-27 14:57
 6:30
6:30
2018-04-03 10:35
 12:51
12:51
2024-11-27 16:39
 11:00
11:00
2022-04-01 17:59
 12:12
12:12
2024-11-29 14:21
2021-09-22 22:45
 6:48
6:48
2025-10-17 10:00
2021-09-22 23:37
2021-09-22 22:54
 12:41
12:41
2024-11-28 12:54
2021-09-22 21:17
 11:06
11:06
2022-04-01 15:56
2021-09-22 23:25
2021-09-22 21:43
 13:00
13:00
2024-12-02 13:15
 45:30
45:30
2025-09-17 18:49
 7:09
7:09
2023-07-06 19:20
 1:05:35
1:05:35
2025-10-31 17:03
 11:20
11:20
2025-09-12 10:05
2021-09-22 23:09
0/0

